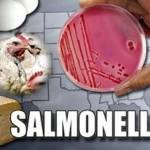
Сальмонеллез

Болевой синдром в области ЖКТ может возникать по разным причинам. Боль, как правило, сопровождается такими признаками, как рвота, тошнота, озноб, понос. Многие люди справляются с подобной симптоматикой собственными силами, однако важно понимать, что качественное лечение можно получить только при условии достоверного диагноза, определить который может только квалифицированный врач.
Клиническая картина
Для того, чтобы врач смог установить причину патологического состояния, необходимо обратить внимание на локализацию боли, а также сопутствующие симптомы.
Боли в нижней части живота и диарея
Ноющие и режущие болезненные ощущения в сочетании с поносом и слабостью могут указывать на ряд заболеваний, в том числе на язвенный недуг двенадцатиперстной кишки и желудка. Если причиной симптоматики выступает данная патология, боли наблюдаются спустя 30-40 минут после приема пищи. В основном, дискомфорт появляется из-за употребления кислой, острой продукции.
Причиной возникновения боли может быть также аппендицит. Воспаление отростка слепой кишки (аппендикса) сопровождается интенсивной болью в нижней правой части живота, которая усиливается при нажатии. При данном недуге требуется срочная госпитализация и хирургическое вмешательство. Если своевременно не вызвать скорую помощь, аппендикс может лопнуть, в результате чего может развиться перитонит – воспаление всей брюшной полости. Дополнительным симптомом аппендицита может бить и рези в животе с поносом.
Указанная симптоматика может возникать и при кишечной интоксикации. Проблемы с функционированием кишечника сопровождаются схваткообразными болями, диареей.
Понос, боль в животе и температура
Кишечная инфекция имеет следующие проявления: диарея, болевой синдром и повышенная температура. Причиной подобного инфицирования служит вирус, попадающий в желудок с пищей. Сопутствующие симптомы патологии: тошнота, головная боль, рвота, сильная слабость, утомляемость, болезненность в мышцах. В это время желательно отказаться от еды. Показано обильное питье. Требуется консультация доктора и последующее лечение.
Подобные признаки бывают также при дизентерии. Температура тела может подниматься до 40 градусов. Помимо основной симптоматики, наблюдается рвота и лихорадка. В данной ситуации нужна неотложная врачебная помощь.
Диарея, рвота и боль
Болезненные ощущения, диарея и рвота отмечаются при энтерите. Также наблюдается тахикардия, сильное обезвоживание всего организма. В основном, причиной недуга служит неправильное питание, дефицит витаминов, белка в рационе. Происходит сбой в деятельности тонкой кишки. При энтерите показано: обильное питье, клизмы очистительные, регулярное и сбалансированное питание, вяжущие средства.
Рвота, понос и болезненность — частые спутники колита и пищевого отравления. Причиной отравления служит обычно некачественная пища, попавшая в желудок. Подобная продукция содержит в себе токсины, которые оказывают негативное воздействие на пищеварительный тракт, работу всех органов и систем. Наблюдается недомогание, головокружение, тошнота и слабость. Отравление бывает трех видов: вирусное, химическое и бактериальное. Для решения проблемы делают промывание и обращаются за врачебной помощью. Врачами рекомендована клизма, промывание желудка раствором марганца, а также обильное питье.
Колит сопровождается интенсивной болью в животе, рвотой, тошнотой, поносом, общим недомоганием. Причина возникновения заболевания – проникновение болезнетворных микроорганизмов в желудок. Во время колита преобладает диарея со слизью, кровью. Недуг может быть хроническим. Запор, боли в животе и рвота могут указывать на такие недуги, как цистит, гепатит, гинекологические патологии.
Интересно почитать: какие заболевания сопровождаются болью в животе и рвотой.
Оказание первой помощи
Все перечисленные клинические проявления возникают на фоне протекания различных заболеваний. Прежде чем начать курс лечения, следует посетить врача, сдать анализы и пройти полное обследование. После постановки врачом диагноза можно начинать прописанное лечение. Не следует заниматься самолечением, так как многие заболевания протекают со схожей симптоматикой. Самостоятельное назначение медикаментов может усугубить течение болезни.
Чтобы избавиться от признаков болезни желудочно-кишечного тракта можно выпить активированный уголь. Дозировка, следующая: на 10 килограмм веса — 1 таблетка угля. Он обладает абсорбирующим свойством, благодаря которому легко впитывает патогенные элементы и выводит их из организма.
Также рекомендовано пить солевые растворы. Благодаря этим медикаментозным средствам восстанавливается солевой баланс, предотвращается обезвоживание организма. Болезненные ощущения можно устранить с помощью таких спазмолитиков, как Но-Шпа, Спазмолгон.
При наличии подозрительных симптомов желательно вызывать скорую помощь. Врач сможет установить причину патологии и назначить терапию, которая будет гораздо эффективнее самолечения.

Источник
На первый взгляд головная боль, понос и высокая температура имеют мало общего: температура повышается обычно при вирусных инфекциях дыхательных путей.
В тоже время понос свидетельствует о кишечных расстройствах, а головная боль бывает при повышении артериального давления или переутомлении.
В действительности врачам нередко приходится сталкиваться именно с таким сочетанием жалоб пациентов.
Подобные симптомы могут говорить о развитии самых разных заболеваний в организме. И каждый из них очень важен при постановке диагноза.
Так, например, понос – это симптом пищевого отравления или дизентерии. Но если к нему присоединяется высокая температура, можно также подозревать брюшной тиф или ротавирус. Головная боль является одним из типичных признаков общей интоксикации организма, и может сопровождать практически любую патологию.
Интоксикация организма возникает как при отравлении продуктами или химическими веществами, так и при гриппе. Вызывается она продуктами жизнедеятельности патогенных микроорганизмов, которые активно размножаются при инфекционных заболеваниях.
При каких болезнях возникают головная боль, температура и понос

Медлить нельзя, так как состояние при отсутствии адекватного лечения может стремительно ухудшаться. Только врач установит истинную причину недомогания и подберет необходимые медикаменты.
Причины, которые могут вызывать головную боль, понос и высокую температуру:
- Острые бактериальные кишечные инфекции;
- Вирусные инфекции;
- Брюшной тиф.
В некоторых случаях установить возбудителя патологии, которую сопровождают понос, головная боль и температура, невозможно. В этом случае проводится общая терапия для устранения опасных симптомов и нормализации состояния пациента.
Во всех остальных случаях лечение будет зависеть от возбудителя болезни.
Дизентерия
Это достаточно распространенное кишечное заболевание, вызванное инфекцией. Чаще от него страдают в летний сезон, заражение происходит через немытые овощи и фрукты, песок, речную или морскую воду, но возможно и контактное заражение. Высокая температура воздуха способствует активному размножению микробов и стремительному течению болезни.
Основной симптом дизентерии – понос. Возникает по причине поражения толстого кишечника бактерией шигеллезой. Проявляется дизентерия такими симптомами:
- Тошнота и рвота.
- Понос и частые позывы к опорожнению кишечника.
- Отвращение к пище.
- Высокая температура тела.
- Сильная головная боль.
- Учащенное сердцебиение.
Вначале зараженного человека лихорадит, появляются кишечные расстройства, рези в животе, стул жидкий и водянистый. В каловых массах могут быть примеси крови или слизи. Головная боль при ОРВИ возникает позднее, на фоне интоксикации организма.
Острая дизентерия развивается за 1-2 суток, основная опасность заключается в быстром обезвоживании организма из-за практически непрерывной диареи.
Возможны такие осложнения, как растяжение и выпадение прямой кишки, острая почечная недостаточность, не исключается летальный исход при отсутствии своевременной медицинской помощи.
Сальмонеллез
Это заболевание также является острой кишечной инфекцией, но вызывает его сальмонелла. Пути заражения те же, что и при дизентерии:
- Орально-фекальный;
- Пищевой;
- Бытовой.
Основным и первым симптомом сальмонеллеза является диарея и другие пищевые расстройства. Каловые массы по цвету и консистенции напоминают болотную тину, они жидкие, зеленоватые, с большим количеством слизи.
Обезвоживание при сильной диарее и рвоте может наступить за несколько часов, пациент сильно ослабевает, могут возникать и головные боли.
Осложнение сальмонеллеза:
- Отек головного мозга.
- Анурия.
- Дисфункция почек.
Для постановки диагноза обязательны лабораторные исследования рвотных и каловых масс, крови и мочи.
Ротавирусная инфекция
Ротавирусная инфекция – это кишечный грипп, вызванный заражением ротавируса. Страдают при этом желудок и кишечник, поэтому кроме классических симптомов гриппа возникают также диарея и рвота.
В отличие от кишечных инфекций, ротавирусом заражаются преимущественно в осенне-зимний сезон. Подхватить инфекцию можно орально-фекальным или воздушно-капельным путем. Инкубационный период может длиться до пяти суток. Потом появляются такие симптомы:
- Диарея и рвота;
- Боли в животе;
- Головные боли и боли в горле при глотании;
- Повышение температуры тела;
- Покраснение слизистой гортани;
- Насморк и заложенность носа.

Поскольку аппетит при такой патологии отсутствует, с прогрессированием заболевания пациент сильно страдает от изнуряющей рвоты на пустой желудок.
Если отмечаются классические симптомы гриппа, но при этом у пациента частый и жидкий стул, в первую очередь подозревается ротавирус.
Но подобные проявления могут возникать также при инфицировании аденовирусом, астровирусом, норовирусом. Точно определить возбудителя можно только с помощью лабораторных исследований.
Поэтому при подозрении на ротавирус или любой другой, когда к симптомам гриппа присоединяются расстройства со стороны пищеварительной системы, больной госпитализируется в обязательном порядке.
Методы лечения при поносе, головной боли и температуре
Лечение будет разным в зависимости от возбудителя болезни. При острой кишечной инфекции терапия включает такие моменты:
- Соблюдение постельного режима.
- Диета – в первый день можно только подсоленный рис на воде, рисовый отвар, некрепкий сладкий чай, сухарики, потом постепенно вводятся «тощее» картофельное пюре, протертые отварные овощи и супы. Воспрещены кисломолочные продукты, мясо, рыба, кондитерские изделия, газировка.
- Прием антибактериальных препаратов – подбираются лекарства из той группы, к которым чувствителен возбудитель болезни, это может быть Бисептол, Левомицитин, Ампициллин, при сальмонеллезе назначаются фторхинолоны.
- Симптоматические препараты при кишечных расстройствах и диарее – Лоперамид, Имодиум.
- Обезболивающие и жаропонижающие средства при температуре и головных болях – Нурофен, Цитрамон, Анальгин.

Тактика лечения ротавирусной инфекции отличается. Вирусы нечувствительны к антибактериальным препаратам, потому их принимать не имеет смысла. В первую очередь пациенту обязательно дают сорбенты, или вводят их внутривенно, если он находится в тяжелом состоянии.
Обязательно проводится дегидратация – восстановление водно-солевого баланса в организме. Очень хороши для этого порошки для приготовления раствора Электролит или Регидрон. Их принимают внутрь. Но если обезвоживание очень сильное, то больной госпитализируется и ему вводят внутривенно физраствор и глюкозу.
Температуру при ротавирусе не снижают, если она не выше 38,5 градусов – именно при такой температуре вирусы гибнут, если ее сбить, лечение может значительно затянуться. Нужно придерживаться строгой диеты, исключаются все продукты, которые могут раздражать желудок и кишечник, в том числе и кисло-молочные.
Противовирусные препараты принимаются только после того, как остановлены рвота и диарея, иначе активные вещества просто не будут успевать усваиваться.
Если головная боль и температура сопровождаются поносом, это в большинстве случаев связано с кишечными бактериальными инфекциями. Иногда при заражении вирусами может поражаться желудочно-кишечный тракт.
Важно не допустить обезвоживания организма, поэтому следует сразу же обращаться к врачу и делать анализы, чтобы наверняка установить возбудителя инфекции и начать лечение как можно раньше. Подробно о ротавирусной инфекции расскажет видео в этой статье.

Источник
Понос — это состояние, при котором у больного наблюдается слишком частая дефекация, стул при этом становится водянистым.
Данное состояние опасно тем, что в организме может произойти обезвоживание.
Причины поноса у взрослых
Понос у взрослого может быть связан с наличием глистов или дисбактериозе в кишечнике. К частоте своего стула нужно относиться внимательно, наблюдать за цветом и запахом кала.
В любом случае, понос это следствие того, что кишечник работает неправильно. Пищеварительные процессы ускоряются, возникает частая дефекация.
К распространенным причинам поноса у взрослого относят вирусные и бактериальные инфекции, а также отравления продуктами. Бактерии сальмонеллы являются возбудителями поноса. Они могут находиться в любой пище или воде. Диареей, которая вызывается из-за бактерий часто страдают туристы, так как они намного чаще находятся в экзотических странах. Именно поэтому понос в народе называют «понос туриста».
Также причиной поноса может стать длительный прием антибиотиков, или наличие в организме вируса гепатита или герпеса.
Еще одна причина — язвенный колит. Это заболевание может вызвать понос, однако проявляет оно слишком поздно, и, как правило, только при внутреннем осмотре кишечника.
Так как пищеварительная система находится в плотном контакте с внутренними органами и внешней средой, то можно смело говорить о зависимости от них. Малейший сбой в работе, приводит к раздражению и появлению выделений в виде слизи, а в итоге просто к поносу.
Самые распространенные причины поноса у взрослого:
1. Бактериальные инфекции.
2. Инфекции вирусного типа.
3. Заболевания желудочно-кишечного тракта.
4. Аутоиммунные заболевания, например атопический дерматит, ревматоидный артрит.
5. Разрастания в виде опухоли.
6. Влияние медикаментов.
7. Интоксикация.
8. Кровотечения в желудочно-кишечном тракте.
Понос и температура у взрослого
Понос и температура это достаточно частые явления наблюдающееся у взрослых. Это свидетельствует о сбое в работе пищеварительной системы, а также о наличии каких-либо заболеваний. Поэтому если вы столкнулись с таким явлением, как понос сопровождающийся температурой, то прочитать статью чуть ниже будет просто необходимо. Основные причины:
1. Отравления. Частой причиной которая вызывает такое состояние в организме — это отравление. Через 1-12 часов после того как съеден некачественный продукт, наступает интоксикация организма. Поэтому если вы чувствуете сильную слабость, у вас наблюдается понос, сильно болит живот, а на градуснике 37.5, то это будет свидетельствовать об отравлении. Если все эти симптомы сопровождаются еще и рвотой, то вызвать скорую помощь нужно как можно скорее. Данное состояние может привести к обезвоживанию в организме, а в итоге к летальному исходу.
2. Панкреатит, расстройство кишечника. Понос и температура немного реже являются следствием воспаления поджелудочной железы. Все это возникает в результате неправильного питания, диеты или большим объемом съеденной пищи. Температура может повыситься до 38 градусов, при этом произойдет потеря аппетита, тошнота, понос. В данном случае нужно принимать больше жидкости, не кушать много еды в течение суток. Желательно приобрести препарат в котором содержатся ферменты. Если в течение двух дней ваше состояние останется без изменения, нужно как можно скорее обратиться к врачу.
3. Ротовирусная инфекция. Иначе такое состояние можно назвать кишечный грипп. Симптомы такого состояния следующие — понос, повышение температуры. Диарея достаточно сильная — в сутки может достигать 20 раз. Специального лечения для такого состояния нет. Все что нужно делать, это пить больше жидкости. Препараты, которые рекомендуется принимать — смекта, линекс.
Рвота и понос у взрослого
Понос и рвота у взрослого человека могут появиться из-за различных причин. Чаще всего это один из признаков вирусного гепатита, заражения кишечным гриппом или отравлением.
Кишечный грипп иначе можно назвать ротовирусной инфекцией. Это заболевание может передаваться от человека к человеку. Для того чтобы заразиться, достаточно всего несколько часов провести в обществе с больным человеком. Инкубационный период равен максимум 5 дней. Основные признаки: понос и сильная рвота. Из-за этого в организме быстро наступает обезвоживание. Специалисты утверждают, что до сих пор нет единого мнения по лечению данного заболевания. Для того чтобы хоть как то облегчить свое состояние, можно пить смекту и активированный уголь. Кушать в этот период не рекомендуется, так как рвота только усилится.
Пищевые отравления могут быть разными: попадание в организм микробов вместе с пищей, употребление ядовитой животной пищи. Так же появиться понос и рвота может после того, как были съедены продукты, которые хранились в неправильных условиях.
Для того чтобы вылечить такое состояние, врачи промывают желудок. Также на протяжении всего это времени нужно пить много жидкости. Ни в коем случае нельзя кушать продукты, которые могут как-то раздражать желудок.
Понос, рвота, температура у взрослого
Специалисты выделяют несколько причин, которые могут спровоцировать появление поноса, рвоты и температуры у взрослого человека. Самая распространенная — это кишечная инфекция. Наверняка все знают возбудителей данного состояния — холера, сальмонеллез.
Подобное состояние в организме возникает по следующим причинам:
• человек пьет некипячёную воду;
• руки перед едой не моются;
• пациенты кушают некачественные продукты.
Возникновение рвоты, поноса и температуры у взрослых при инфекциях, как правило, многократно, и всегда такое состояние связано с употреблением некачественных продуктов. Кал может изменить свой цвет и стать зеленым (при сальмонеллезе), желтым (при эшерихиозе). Температура может повышаться до разных отметок. Живот начинает сильно крутить, чувствуется его вздутие, при этом сильной боли не возникает.
Употребление в пищу грибов может спровоцировать появление рвоты, температуры и поноса. Причем маринованные грибы, которые были расфасованы на заводе, отравлений вызвать не могут. Несъедобные грибы могут не только спровоцировать такое состояние, но и быть источником угрозы для жизни. Нельзя медлить ни минуты, как можно скорее посетите своего лечащего врача.
Понос у взрослого без температуры
Достаточно часто пациенты сталкиваются с такой ситуацией, когда у них возникает понос, при этом общее состояние организма остается в норме. Но, что в данной ситуацией служит причиной такого состояния?
Нередко причиной является невротическое состояние. Возникновение стрессовых ситуаций может привести к тому, что организм даст ответную реакцию. Вместе с поносом может сильно болеть голова. Такие ситуации могут возникать перед важными событиями, например перед приобретением чего-то ценного. Если такое состояние организма продолжается на протяжении нескольких дней и нет ни каких улучшений, то нужно пойти к невропатологу. Именно он может обследовать, выявить истинную причину и назначит лечение.
Еще одна распространенная причина появления поноса без температуры — это ненормальная работа желудочно-кишечного тракта или его заболевания. Например, это может быть язва желудка, гастрит. Выявить проблему можно по вздутию живота, которое появится сразу после того как вы покушаете. Также появиться сильная боль в животе и изжога. Если у вас появились все эти симптомы, нужно пойти на обследование к гастроэнтерологу. Все, что касается заболеваний желудочно кишечного тракта, обязательно нужно обследовать, и нельзя оставлять без внимания.
Иногда понос у взрослого вместе с рвотой, может появиться вследствие приема определенных лекарств. Об этом нужно сообщить своему врачу, для того чтобы он выписал другие препараты, аналогичные этим.
Независимо от того, чтобы послужило причиной развития поноса без температуры, необходимо как можно скорее приступить к лечению. В противном случае произойдет обезвоживание организма.
Понос и рвота без температуры у взрослого
Ни один взрослый человек не застрахован от того, что у него может появиться понос и рвота, но при этом температура тела будет нормальная. Причин для этого явления достаточно много:
1. Пищевое отравление. Главное вовремя выявить продукт, который спровоцировал такую реакцию организма. Также нужно пить больше теплой кипяченой воды.
2. Кишечный грипп. Повышение температуры возможно, но в редких случаях.
Не только эти факторы являются причинами возникновения поноса и рвоты, но и многие заболевания:
1. Гастрит.
2. Панкреатит.
3. Энтероколит.
Кроме вышеописанных признаков, а именно рвоты и тошноты, может ощущаться боль в животе. Самостоятельно справиться с таким состоянием вряд ли получится. Важно своевременно обратиться к специалистам, чтобы в организме не возникло других, более серьезных осложнений. Если самостоятельно пойти в больницу вы не можете, так как большую часть своего времени вынуждены проводить в туалете, то можно вызвать скорую помощь.
Лечение поноса у взрослых
При обращении в медицинское учреждение, специалисты назначат вам терапевтические методы лечения. В первую очередь оно направлено на основную болезнь, которая и послужила возникновению поноса у взрослого. Вместе с этим назначают медикаментозные средства. Все закрепляющие средства врачи разделяют на пять основных групп:
1. Лекарственные препараты способные оказать действие на моторику кишечника (лоперамид). Данные средства включают в себя опий и все его производные. Лекарство является лучшим в лечении поноса, так как оно самое эффективное, а главное не имеет наркотических средств. Независимо от того, сколько дней вы будете его применять, организмом он будет переноситься хорошо.
2. Адренергические препараты. Если лечить понос у взрослых эффективно холинолитиками.
3. Анти секреторные препараты. К ним относят ингибиторы.
4. Средства способные уплотнить кал. Лекарственные препараты использовали еще в древние времена. Активно применялся кальций карбоната. Он связывает все жирные кислоты в нашем кишечнике, благодаря этому кал вновь становится плотным. Можно также принимать активированный уголь. Но поможет он только в том случае, если выпить его в правильной дозе.
5. Препараты позволяющие выводить желчные кислоты вместе с каловыми массами. Для этого применяют такие лекарства как лингин и алмагель.
Не все средства, которые перечислены, являются, эффективны для каждого больного. Так как организм каждого человека индивидуален, и подобрать нужное лекарство может только врач после проведения полного обследования. Самостоятельно принимать какие-либо лекарства не стоит, так как это может только ухудшить ситуацию.
Народные средства от поноса у взрослых
Все народные средства нужно применять только в сочетании с диетой. При наличии поноса у взрослого человека ограничьте его рацион питания легкой пищей. Кишечник должен легко усваивать все продукты, поступившие в него.
Ни в коем случае не стоит кушать жареные, копченые или слишком соленые продукты. Не забывайте о количестве выпиваемой жидкости. Ведь именно в этот момент она нужна как ни когда. Как только начался понос, первые часа 3-4 лучше вообще не кушать ничего.
Вот примерный список продуктов которые разрешено употреблять:
• курица или индейка;
• картошка;
• гречневая каша;
• калина или клюква.
Соблюдать диету необходимо не только когда понос находится в стадии обострения, но и в тот период, когда организм восстанавливается.
Несмотря на то, что многие из нас и пытаются умолчать о такой деликатной проблеме как понос, но все-таки это достаточно опасное явление для организма. Начиная лечить его, не забывайте о том, что народные средства могут лишь купировать диарею, но не вылечить ее.
Избавиться от поноса находясь дома можно теми продуктами, которые у каждого из нас находятся на кухне или в аптечке. Все рецепты пришли к нам от наших бабушек, они проверены годами и являются эффективными. Несмотря на то, что способы просты, уже через несколько часов вы почувствуете первое облегчение:
1. Крепкий чай. Одно из лучший народных средств — это крепок заваренный чай. Но лучше использовать не пакетики, а тот, который нужно заваривать. Полученное средство можно выпить сразу, или съесть гущу заварки.
2. Сушка от курочки. Если снять с куриных желудков пленку и высушить ее, то затем можно лечиться ей от поноса. Измельченные пленочки принимают по несколько раз в день.
3. Черный перец. При появлении сильной диареи нужно перед сном положить в рот 10-15 горошин черного перца и запить водой. Проснувшись утром, прежних проблем наблюдаться не должно.
4. Корки граната. Зерна граната способны оказать укрепляющее действие на организм, но наши бабушки для лечения использовали их корки. Необходимо мелко их нарезать, взять 2 столовые ложки и залить одним стаканом воды. После этого поставьте на огонь и прокипятите пол часа. Отвар нужно принимать в количестве двух столовых ложек примерно за 30 минут до приема пищи.
5. Зеленый орех и перегородки. Данное народное средство мы часто отправляем в мусорку и даже не думаем о том, что когда оно может помочь нам справиться с такой проблемой как понос. Настойку на орехах можно хранить долго. Возьмите 100 грамм перегородок от грецких орехов, затем залейте их 150 мл спирта, настаивать это нужно в течение 3 дней. После этого пропустите через марлю, и поставьте в холодильник. Как только у вас появилась диарея, разведите 6 капель настойки в 1/3 стакане кипяченой (холодной) воды и выпейте.
6. Отвар из риса. Именно данному средству отдают наибольшее предпочтение. Ведь отвар из риса помогает даже при самом сильном поносе. Его нужно сварить в воде до тех пор пока не образуется жидкая каша. Ни в коем случае нельзя солить. После того как «блюдо» будет готово, процедите его, и выпейте одну кружку отвара.
Применять домашние средства можно лишь тогда, когда человек уверен — в ближайшие дни у него нет возможности посетить больницу. Но все-таки если диарея протекает вместе с высокой температурой и рвотой, то нужно найти способ поехать к врачу. Понос у взрослого достаточно опасен. О своем организме нужно заботиться, вовремя начинать лечение.
Источник
